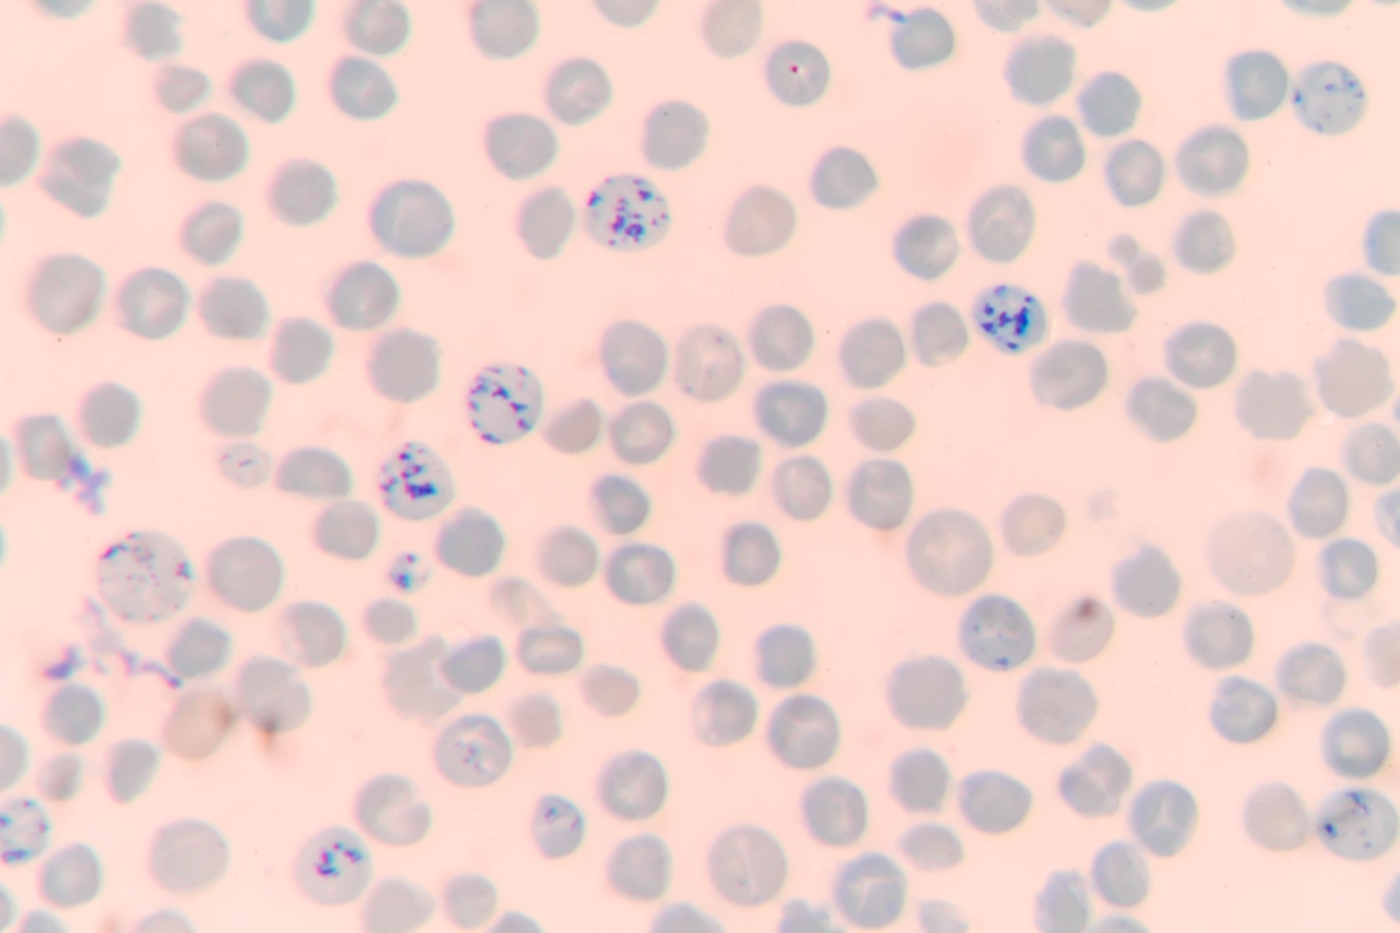
What is the difference between polychromatophilic red cell and a ...

Polychrome Rbc
Support conservation with our environmental Polychrome Rbc gallery of numerous green images. sustainably showcasing photography, images, and pictures. designed to promote environmental awareness. Our Polychrome Rbc collection features high-quality images with excellent detail and clarity. Suitable for various applications including web design, social media, personal projects, and digital content creation All Polychrome Rbc images are available in high resolution with professional-grade quality, optimized for both digital and print applications, and include comprehensive metadata for easy organization and usage. Explore the versatility of our Polychrome Rbc collection for various creative and professional projects. Diverse style options within the Polychrome Rbc collection suit various aesthetic preferences. Whether for commercial projects or personal use, our Polychrome Rbc collection delivers consistent excellence. Instant download capabilities enable immediate access to chosen Polychrome Rbc images. Reliable customer support ensures smooth experience throughout the Polychrome Rbc selection process. Our Polychrome Rbc database continuously expands with fresh, relevant content from skilled photographers. Cost-effective licensing makes professional Polychrome Rbc photography accessible to all budgets. Multiple resolution options ensure optimal performance across different platforms and applications. Comprehensive tagging systems facilitate quick discovery of relevant Polychrome Rbc content. Each image in our Polychrome Rbc gallery undergoes rigorous quality assessment before inclusion.